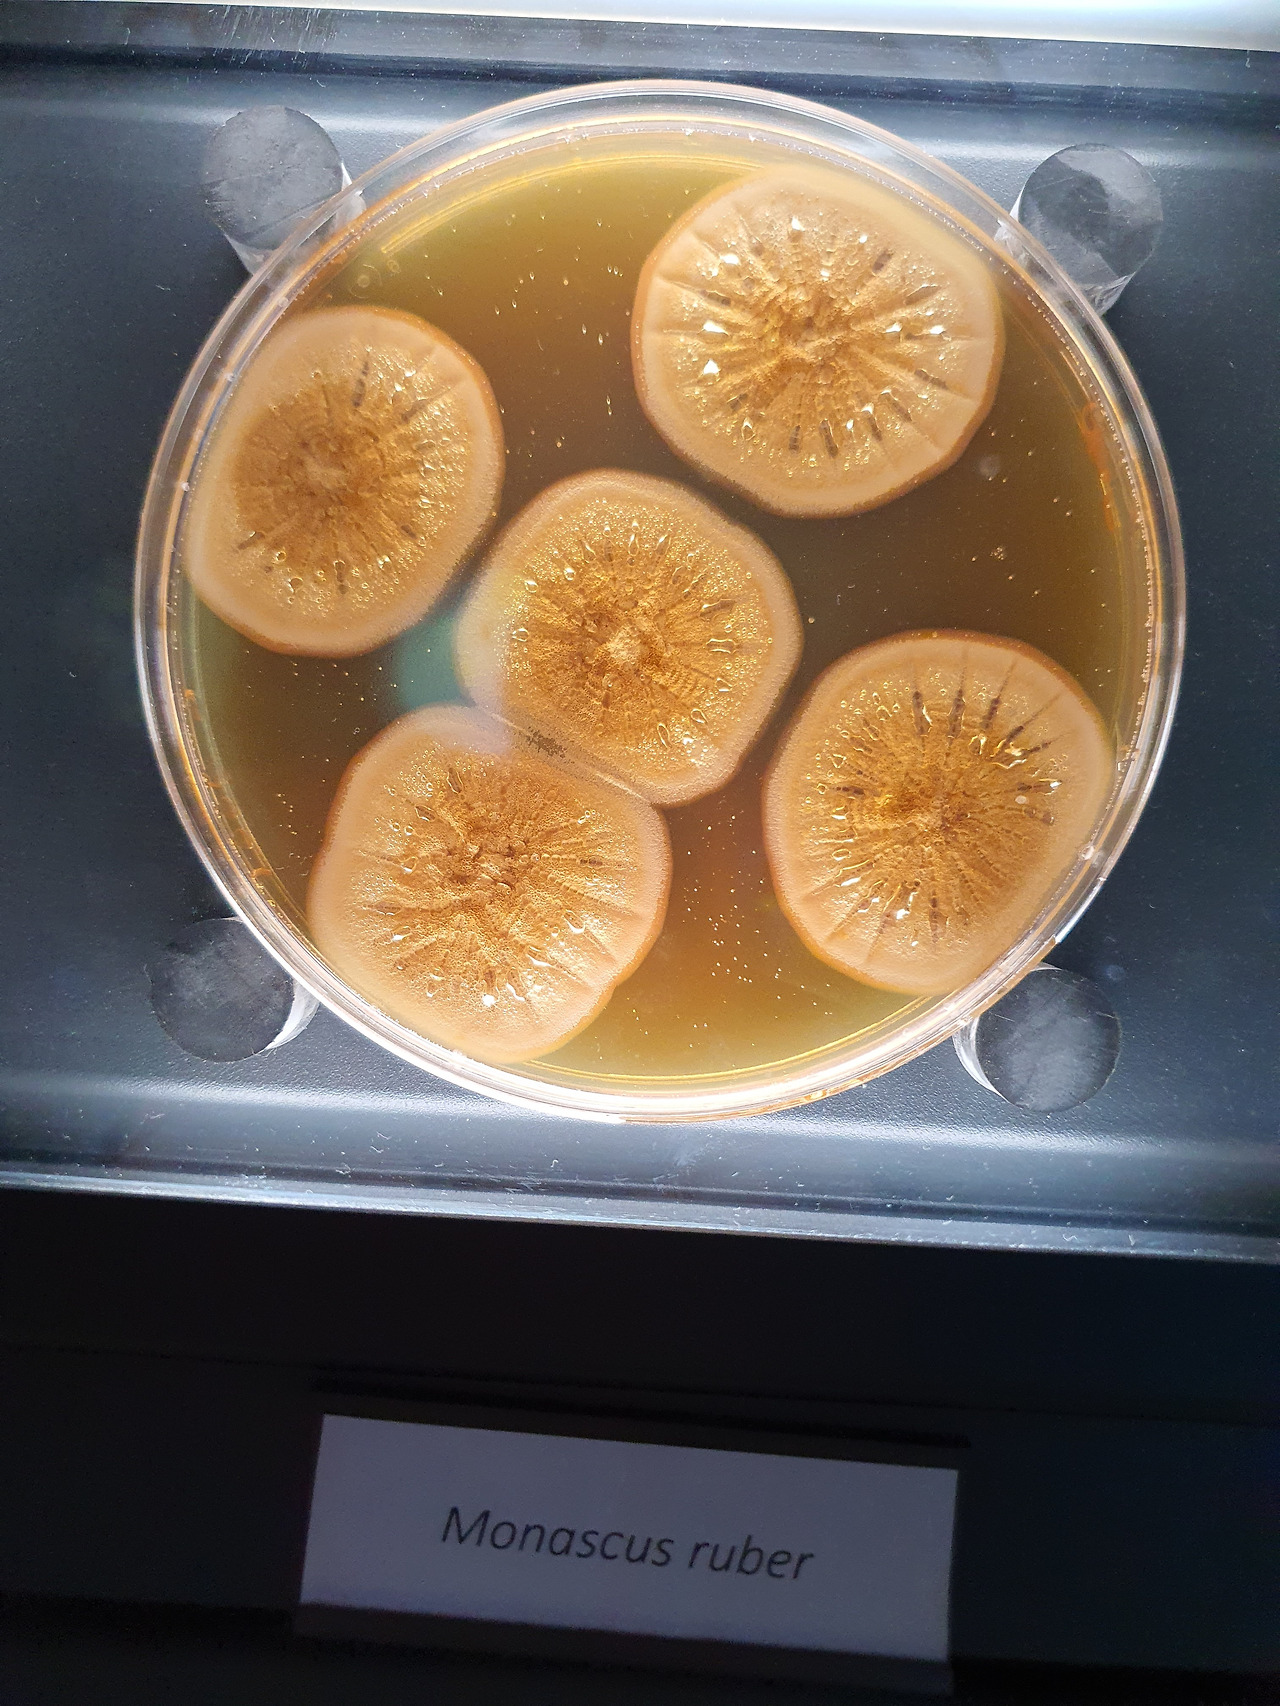
KakaoTalk_20230420_053223050_08.jpg
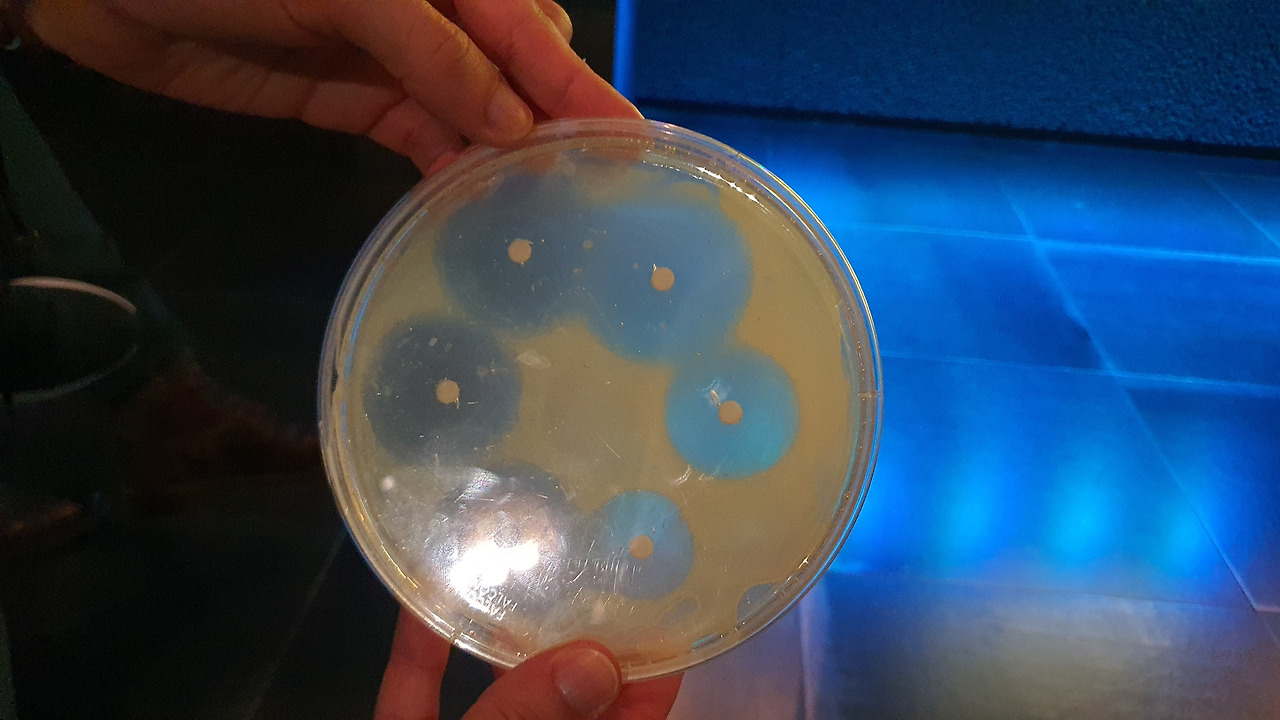
21 KakaoTalk_20230420_053226913_17 (1).jpg

우리도 미생물박물관(2)
우리도 미생물박물관이 필요합니다.
잘 할수 있습니다(1).
https://brunch.co.kr/@seungbeomhong/52
에 이어집니다.
보는 것만 하니 조금 싫증이 날만 하겠습니다.
제 이야기가 아니고 일반 관객이요.
(저야 신났지요 ^-^)
이제 참여 수업입니다.

올라서라고 발자국을 그려 놓은 곳에 서면 내 모습이 화면에 나타납니다. 화면 사진을 찍고 있는 제모습인데요, 제 몸에 1750억개의 미생물이 함께 하고 있다는 이야기 같습니다. 주로 미생물이 많은 곳을 보여 주고 있고요, 영어로도 설명하는데 타이밍을 놓쳐 네덜란드어이네요.
 저야 혼자 갔으니 실습해 볼수가 없었지만 키스하는 장소가 있고, 키스할 때에 미생물의 이동에 대한 설명이 있습니다. 역시 발상이 훌륭하죠 (사진 micropia 홈페이지 인용)
저야 혼자 갔으니 실습해 볼수가 없었지만 키스하는 장소가 있고, 키스할 때에 미생물의 이동에 대한 설명이 있습니다. 역시 발상이 훌륭하죠 (사진 micropia 홈페이지 인용)
그리고 오후에는 2시와 4시, 연구원이 직접 나와서 미생물에 대하여 설명해줍니다. 이야기는 파스퇴르의 미생물 연구부터 시작하더라고요, 그리고 플레밍의 페니실린 발견, 미생물 효소, 분해자 미생물 등등으로 이어 집니다.
 곰팡이가 만든 항생제에 의하여 세균이 죽은 배양기를 실제 나누어주면서 가까이서 보라고 합니다.
곰팡이가 만든 항생제에 의하여 세균이 죽은 배양기를 실제 나누어주면서 가까이서 보라고 합니다. 
낮시간이었는데도 듣는 사람이 꽤 많네요. 왼쪽 분이 설명하는 학예사(이들은 Technition이라고 하더라고요) 그리고 어른과 아이가 함께 열심히 듣고 있네요. 저도요! 오른쪽 아래가 제자리이고 제가방입니다.

그리고 기획전시라고 하나요!
이달의 미생물을 선정하여 보여주고 설명해주는데,
헐!
그 미생물이 바로 Rasamsonia입니다.
위의 둘째줄을 보세요.
Rasamsonia는 저의 학문적 멘토 Robert A. Samson 박사를 기리기 위하여 만든 속명인데, 마침 그 곰팡이가 이달의 곰팡이로 전시되어 있네요.
저의 방문을 어찌 알고 저를 환영하기 위하여 특별전시해 놓았네요. ^-^


전시공간에 실험실이 바로 붙어 있습니다. 대부분의 전시물들이 다 살아있는 미생물이니 이들을 유지할려면 전문 연구자들이 붙어 있어야겠지요. 저는 Micropia는 미생물박물관 보다는 미생물 실험실 같은 느낌이었습니다.
실험실의 장비들은 그냥 우리가 늘 쓰는 그 장비네요, 클린벤치, 배양기, 현미경 등!
 다음은 요즈음 hot한 마이크로바이옴 관련 전시입니다. 먼저 사람의 장을 직접 보여주고요, 여기의 미생물들을 보여줍니다.
다음은 요즈음 hot한 마이크로바이옴 관련 전시입니다. 먼저 사람의 장을 직접 보여주고요, 여기의 미생물들을 보여줍니다.

대표적인 프로바이오틱스 미생물인 유산균입니다.

그리고 똥 전이?
뭐라고 번역해야 합니까? 건강에 문제가 있는 사람의 똥을 제거하고 건강한 사람들이 똥을 이식하는 행위를. 이에 대하여 설명해 주고 있습니다.
 그리고 우리가 일상 생활에서 사용하는 물건들에 어떤 미생물들이 있는지도 보여줍니다.
그리고 우리가 일상 생활에서 사용하는 물건들에 어떤 미생물들이 있는지도 보여줍니다.
이건 매우 익숙한 사진이죠?

농업미생물과에서 몇년전에 전시했던 사진입니다. 이 전시는 마이크로피아와는 관련이 없는 우리의 독창적인 아이디어 였습니다. 내용과 수준이 우리가 한 수 위죠 ^-^ (사진 김남정 박사 페이스북 인용)
 Micropia의 글씨도 보이고요,
Micropia의 글씨도 보이고요, 홍국균도 보입니다. 다양한 곰팡이 세균이 있고요, 이것만 보고 있어도 시간이 금방 갑니다.
홍국균도 보입니다. 다양한 곰팡이 세균이 있고요, 이것만 보고 있어도 시간이 금방 갑니다. 이제 2층 구경을 마치고 1층으로 내려오는데요, 1층의 한 면을 우리가 배양기에서 흔히 보는 곰팡이로 장식을 해 놓았네요.
이제 2층 구경을 마치고 1층으로 내려오는데요, 1층의 한 면을 우리가 배양기에서 흔히 보는 곰팡이로 장식을 해 놓았네요. 유리공예가가 만든 세균 조형물입니다.
유리공예가가 만든 세균 조형물입니다. 역시 유리로 만든 박테리오파아지 입니다. 말그대로 예술입니다. 유리로 어떻게 이렇게 정교하게 만드는지?
역시 유리로 만든 박테리오파아지 입니다. 말그대로 예술입니다. 유리로 어떻게 이렇게 정교하게 만드는지?미생물 조형물에 넉을 놓고 보고 있는데, 이제 곧 문을 닫는다고 하네요.
왜? 이제 5시인데!
6시까지 관람이 가능한 줄 알았는데.
1층에는 미생물의 산업적 활용부분인데,
자세히 볼 것이 많은데 어떡하냐!
내일 안되는데!

후딱 둘러보니 바이오에탄올에 대한 전시물이 있습니다.

그리고 미생물 비료와 농약!
농업미생물과가 하는 바로 그 일인데!
자세히 봐야 하는데 나가야 하다니 ㅠㅠㅠ.

정말이지 눈물을 머금고 나오는데,
짠돌이 네덜란드 사람들이 역시 물건을 팔아야지.
다양한 미생물 산물들이 판매되고 있습니다.
술도!

눈에 들어오는 것이 배지!
5유로 정도 하는데 배지를 가지고 가서 실제 미생물 한번 키워 보라는 것입니다.

역시 일본은 대단한 나라!
발효음식에 관련된 책으로 숟가락 하나 올렸습니다.
반고호박물관을 가도 동시대의 일본 대나무 그림이 전시되어 있습니다. 물론 당시에 반고호가 일본과의 교류가 조금은 있었다지만 이는 일본 관광객을 위한 배려, 일본은 자기네 물건이 있으니 자부심을 느껴서 좋고, 네덜란드는 일본을 우대해 주어 좋고, 그리고 덤으로 일본관광객이 더 찾아와 좋습니다.
네덜란드와 일본,
대단히 실용적인 국가들입니다.
마이크로피아를 나오니 바로 동물원, 홍학이 여유롭게 거닐고 벚꽃이 활짝 피었습니다.
이상으로 마이크로피아에 대하여 간단히 소개합니다. 다른 목적으로 온 것이기에, 일을 빨리 끝내고 살짝 방문한 것이기에 마이크로피아에 대한 사전 조사도 없었고, 방문 후에도 뭐 더 보탤 것도 없이 찍은 사진만 올립니다(후에 공부하여 보완할 기회가 있으면 좋겠슴다).
하지만 이런 느낌은 오네요.
이거 돈 되겠다!
그리고 우리도 할 수 있다.
실제 우리 이런 전시 많이 해왔다.
2030년 경에
과천동물원 옆자리에
미생물박물관을 꿈꿔봅니다!